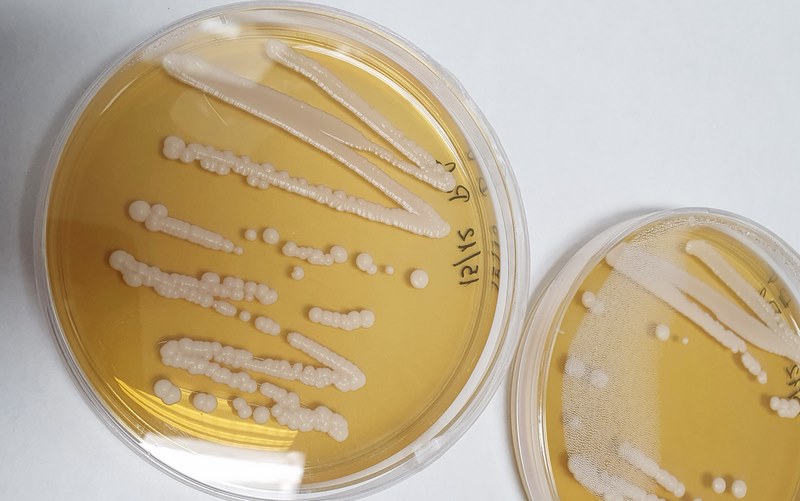

No proxecto participan investigadoras e investigadores das universidades de Vigo, A Coruña e Murcia
Os grupos de investigación da Universidade de Vigo Food and Health Omics (CF1) e Investigacións Agroalimentarias e Ambientais (AA1) xunto con investigadores da Universidade da Coruña e a Universidad de Murcia están a desenvolver un proxecto estatal no que analizan o efecto dos funxicidas sobre a microbiota fermentativa (lévedos e bacterias vínicas) e as súas repercusións na calidade sensorial dos viños brancos. “A presencia no viño de residuos dos produtos fitosanitarios aplicados no viñedo é un feito consumado e aínda que, normalmente, estes se atopan en concentracións baixas, o que permite garantir a súa calidade hixiénico sanitaria, poderían alterar as rutas metabólicas da microbiota fermentativa modificando o perfil aromático dos viños producidos”, explica o equipo investigador.
O proxecto, financiado na convocatoria de 2019 de Proxectos de I+D+i, na modalidade Retos de Investigación, do Ministerio de Ciencia e Innovación, ten unha duración de tres anos e arrancou en setembro de 2020 co nome de Funvine. Nel, o equipo investigador, liderado por Jesús Simal, catedrático na Área de Nutrición e Bromatoloxía, e Raquel Rial, profesora titular da mesma área de coñecemento, céntrase na análise dos mecanismos moleculares que regulan a resposta da microbiota fermentativa á presencia de residuos de funxicidas e as súas respectivas formulacións comerciais e como estas modificacións a nivel molecular se traducen en cambios na calidade sensorial dos viños. Con el dáse continuidade ás liñas de investigación previas destes grupos de investigación centradas no estudo das repercusións agrarias e alimentarias da aplicación de funxicidas no viñedo. A iniciativa conta coa colaboración do grupo de Biotecnología de Alimentos do Instituto de Agroquímica y Tecnología de Alimentos (IATA) de Valencia.
Coñecemento para impulsar o sector
Segundo explican os seus responsables, Funvine pretende contribuír a “impulsar o sector vitivinícola español a través dun maior coñecemento sobre o efecto dos funxicidas sobre a microbiota fermentativa e a calidade sensorial dos viños”. Só un mellor coñecemento destes aspectos, recalcan, “permitiralle ao sector modular os procesos de produción para obter produtos diferenciados que poidan ser máis competitivos no mercado”. Ademais, engaden, “un maior coñecemento do papel que desempeñan os coadxuvantes das formulacións comerciais pode tamén resultar de interese para os fabricantes de produtos fitosanitarios, xa que lles permitirá adaptar as formulacións co fin de limitar o seu impacto sobre a microbiota fermentativa e a calidade dos viños obtidos”. Estudos previos, detalla o equipo que realiza o estudo, poñen de manifesto que a presencia de residuos dalgúns funxicidas no mosto, aínda a concentracións inferiores aos límites máximos de residuos establecidos en vinificación pola lexislación europea, pode condicionar a evolución do curso fermentativo e o perfil aromático dos viños obtidos. Asemade, engaden as e os investigadores, “tense observado que a magnitude dos cambios depende do funxicida considerado e da súa concentración no mosto” e que “os cambios poténcianse ao empregar as formulacións comerciais fronte ao uso das substancias activas de forma individual, o que parece indicar que o resto de coadxuvantes presentes na formulación comercial tamén poderían xogar un papel relevante nestes procesos”. Segundo explica Raquel Rial, “os estudos que estamos levando a cabo amosan que os residuos de funxicidas, incluso en concentracións inferiores aos límites máximos de residuos, poden alterar a expresión xénica dos lévedos e modificar a abundancia de certas encimas clave na biosíntese de compostos aromáticos, o que, en último termo, repercute na calidade organoléptica dos viños obtidos”. Ademais, engade a investigadora, “estamos estudando os posibles efectos sinérxicos ou aditivos que se derivan da aplicación conxunta das substancias activas con actividade antifúnxica e os coadxuvantes presentes nas formulacións comerciais”.
Estudos previos, detalla o equipo que realiza o estudo, poñen de manifesto que a presencia de residuos dalgúns funxicidas no mosto, aínda a concentracións inferiores aos límites máximos de residuos establecidos en vinificación pola lexislación europea, pode condicionar a evolución do curso fermentativo e o perfil aromático dos viños obtidos. Asemade, engaden as e os investigadores, “tense observado que a magnitude dos cambios depende do funxicida considerado e da súa concentración no mosto” e que “os cambios poténcianse ao empregar as formulacións comerciais fronte ao uso das substancias activas de forma individual, o que parece indicar que o resto de coadxuvantes presentes na formulación comercial tamén poderían xogar un papel relevante nestes procesos”. Segundo explica Raquel Rial, “os estudos que estamos levando a cabo amosan que os residuos de funxicidas, incluso en concentracións inferiores aos límites máximos de residuos, poden alterar a expresión xénica dos lévedos e modificar a abundancia de certas encimas clave na biosíntese de compostos aromáticos, o que, en último termo, repercute na calidade organoléptica dos viños obtidos”. Ademais, engade a investigadora, “estamos estudando os posibles efectos sinérxicos ou aditivos que se derivan da aplicación conxunta das substancias activas con actividade antifúnxica e os coadxuvantes presentes nas formulacións comerciais”.
Un lévedo e unha bacteria láctica
As e os investigadores da Facultade de Ciencias do campus de Ourense centran o seu estudo en varios obxectivos específicos. O primeiro deles é identificar que outros compoñentes das formulacións comerciais poden potenciar a acción dos funxicidas e entender os seus efectos sobre o metabolismo dun lévedo Saccharomyces cerevisiae, a composición e fluidez da súa membrana plasmática e a síntese de compostos aromáticos derivados do seu metabolismo secundario. “A cepa de lévedo comercial elixida foi seleccionada en base ás súas especiais características: forte carácter competitivo, capacidade para fermentar a baixa temperatura, boa floculación e excelente tolerancia ao alcohol. Isto permite que sexa unha cepa axeitada para ser empregada nunha ampla gama de aplicacións, incluíndo a vinificación de viños brancos e tintos”, sinalan desde o Funvide. Igualmente no proxecto avaliarán o efecto dos funxicidas sobre outros lévedos vínicos co fin de testar se os efectos observados no elixido son consistentes cos observados noutras cepas.
O equipo da UVigo tamén ten entre os seus obxectivos avaliar e entender o efecto dos funxicidas sobre o metabolismo da bacteria láctica Oenococcus oeni e a súa influencia no perfil aromático dos viños. “Seleccionouse esta bacteria comercial por ser a máis fiable para o desenvolvemento completo da fermentación maloláctica”, apuntan as e os investigadores. Esta bacteria, detallan, destaca pola súa capacidade para incrementar as notas a froita fresca en viños brancos e tintos e ten demostrado unha alta compatibilidade con moitas cepas de lévedo, facéndoa axeitada para a co-inoculación. Por último, o equipo coordinado por Jesús Simal e Raquel Rial tamén determinará se os efectos observados a escala de laboratorio usando un medio sintético poden ser extrapolados ao que realmente acontece nas bodegas. Para iso, levaranse a cabo procesos de vinificación a media escala empregando uvas brancas da variedade Airén, a variedade máis cultivada en España, e estimaranse as taxas de disipación de residuos de funxicidas ao longo do proceso de vinificación.





